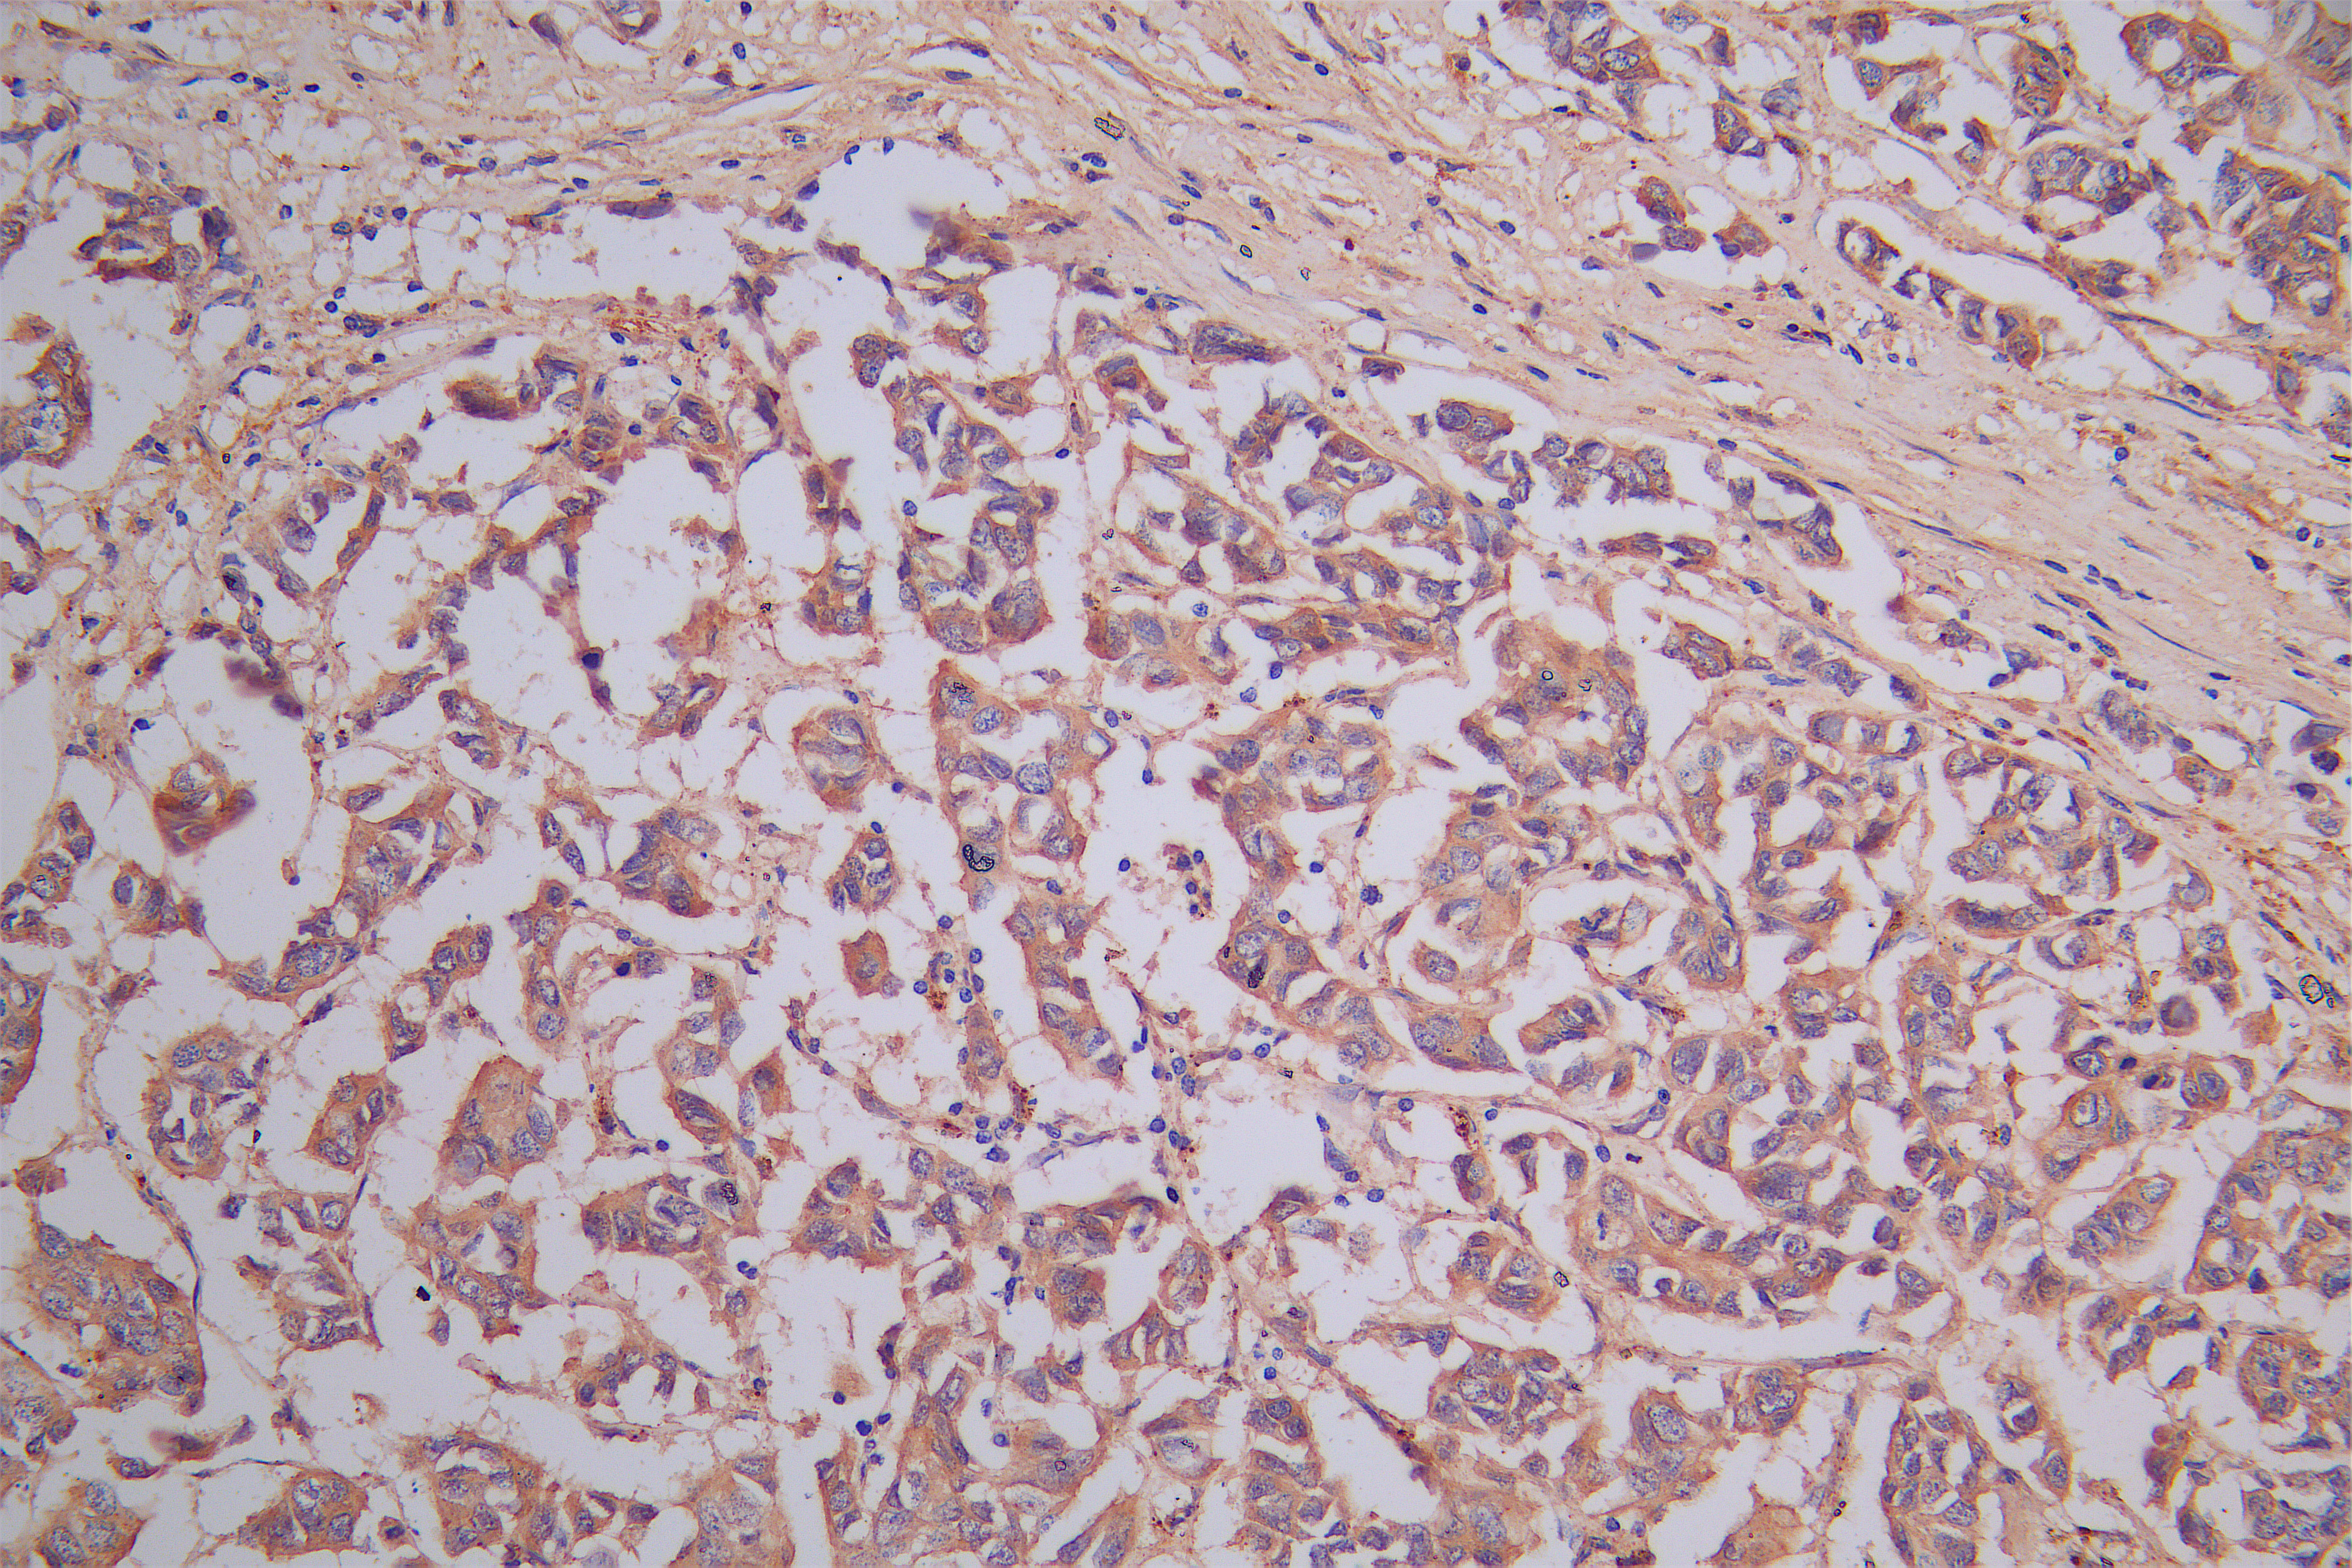

DPYSL2 Recombinant Monoclonal Antibody
-
中文名稱:DPYSL2重組抗體
-
貨號:CSB-RA614975MA1HU
-
規格:¥1320
-
圖片:
-
IHC image of CSB-RA614975MA1HU diluted at 1:150 and staining in paraffin-embedded human brain tissue performed on a Leica BondTM system. After dewaxing and hydration, antigen retrieval was mediated by high pressure in a citrate buffer (pH 6.0). Section was blocked with 10% normal goat serum 30min at RT. Then primary antibody (1% BSA) was incubated at 4°C overnight. The primary is detected by a Goat anti-Rabbit IgG labeled by HRP and visualized using 0.05% DAB.
-
IHC image of CSB-RA614975MA1HU diluted at 1:150 and staining in paraffin-embedded human colorectal cancer performed on a Leica BondTM system. After dewaxing and hydration, antigen retrieval was mediated by high pressure in a citrate buffer (pH 6.0). Section was blocked with 10% normal goat serum 30min at RT. Then primary antibody (1% BSA) was incubated at 4°C overnight. The primary is detected by a Goat anti-Rabbit IgG labeled by HRP and visualized using 0.05% DAB.
-
IHC image of CSB-RA614975MA1HU diluted at 1:150 and staining in paraffin-embedded human breast cancer performed on a Leica BondTM system. After dewaxing and hydration, antigen retrieval was mediated by high pressure in a citrate buffer (pH 6.0). Section was blocked with 10% normal goat serum 30min at RT. Then primary antibody (1% BSA) was incubated at 4°C overnight. The primary is detected by a Goat anti-Rabbit IgG labeled by HRP and visualized using 0.05% DAB.
-
-
其他:
產品詳情
-
產品描述:CSB-RA614975MA1HU DPYSL2重組單克隆抗體是針對二氫嘧啶酶樣蛋白2(DPYSL2)研發的高特異性科研試劑,該靶標蛋白在神經發育及細胞骨架調控中發揮重要作用,與神經退行性疾病及腫瘤進展密切相關。本產品經過嚴格的ELISA和免疫組化(IHC)驗證,在石蠟包埋組織切片中展現出優異的抗原結合能力,推薦使用稀釋比例為1:50-1:200時可獲得清晰的特異性信號,背景干擾低。采用重組單克隆抗體技術生產,確保批次間高度一致性,適用于神經發育機制研究、神經系統疾病(如阿爾茨海默病、精神分裂癥)的病理模型分析,以及癌癥發生發展中細胞遷移調控相關的基礎科研實驗。該抗體為冷凍干燥制劑,需按說明書進行復溶與保存,建議配合陽/陰性對照樣本優化實驗條件。
-
Uniprot No.:
-
基因名:
-
別名:DPYSL2 Recombinant Monoclonal Antibody
-
反應種屬:Human
-
免疫原:Recombinant Human DPYSL2 protein
-
免疫原種屬:Homo sapiens (Human)
-
標記方式:Non-conjugated
-
克隆類型:Monoclonal
-
抗體亞型:Rabbit IgG
-
純化方式:Affinity-chromatography
-
克隆號:1A1
-
濃度:It differs from different batches. Please contact us to confirm it.
-
保存緩沖液:Preservative: 0.03% Proclin 300
Constituents: 50% Glycerol, 0.01M PBS, PH 7.4 -
產品提供形式:Liquid
-
應用范圍:ELISA, IHC
-
推薦稀釋比:
Application Recommended Dilution IHC 1:50-1:200 -
Protocols:
-
儲存條件:Upon receipt, store at -20°C or -80°C. Avoid repeated freeze.
-
貨期:Basically, we can dispatch the products out in 1-3 working days after receiving your orders. Delivery time maybe differs from different purchasing way or location, please kindly consult your local distributors for specific delivery time.
-
用途:For Research Use Only. Not for use in diagnostic or therapeutic procedures.
相關產品
靶點詳情
-
功能:Plays a role in neuronal development and polarity, as well as in axon growth and guidance, neuronal growth cone collapse and cell migration. Necessary for signaling by class 3 semaphorins and subsequent remodeling of the cytoskeleton. May play a role in endocytosis.
-
基因功能參考文獻:
- cross-talk between distinct CRMP2 posttranslational modifications is a key factor in determining NaV1.7 trafficking and localization PMID: 27940916
- crystal structure of human tetrameric CRMP-2 PMID: 28044206
- increased pCRMP2 may underlie the axonal pathology of Lewy body dementias. PMID: 27609071
- These data identify a novel oncogenic mechanism where CDK5 activation induces CRMP2A phosphorylation in the nuclei of tumour cells PMID: 26555036
- polymorphisms of the DPYSL2 gene in humans may be associated with the development of schizophrenia. PMID: 25847191
- Functional variants in DPYSL2 sequence increase risk of schizophrenia and suggest a link to mTOR signaling PMID: 25416705
- Changes for CRMP2, TCP1epsilon, TPM2 and 14-3-3gamma were confirmed in experimental tumors and in a series of 28 human SI-NETs. PMID: 25224486
- Reduced CRMP2 expression and elevated expression of nuclear phosphorylated CRMP2 may be associated with breast cancer progression. PMID: 23381229
- Levels of total GSK3 were decreased in the Huntington disease-affected frontal cortex and this correlated with decreased phosphorylated CRMP2. PMID: 24634145
- High dihydropyrimidinase-related protein 2 expression is associated with lung cancer. PMID: 24518087
- genetic variants in DPYSL2 may play a role in susceptibility to alcohol dependence. PMID: 23846846
- A specific and reversible intermolecular Cys-504-Cys-504 dithiol-disulfide switch in homotetrameric CRMP2 determines two conformations of the quaternary CRMP2 complex that controls axonal outgrowth and thus neuronal development. PMID: 24133216
- CRMP-2-dependent regulation of ROCK II activity is mediated through interaction of the CRMP-2L N terminus with the ROCK II catalytic domain as well as by GSK3-dependent phosphorylation of CRMP-2. PMID: 24036111
- a novel regulatory mechanism that utilizes CRMP2 SUMOylation to choreograph NaV1.7 trafficking. PMID: 23836888
- a new insight into CRMP-2 as a controller of myosin II-mediated cellular functions through the inhibition of ROCK II in nonneuronal cells PMID: 22431514
- No Alzheimer disease-associated differences in CNP and DPYSL2 promoter DNA methylation were observed. PMID: 22954668
- Deletion analysis of CRMP-2 identified a 51 amino acid sequence in the C-terminus that is required for targeting to the basal body and primary cilium. This domain contains GSK-3beta phosphorylation sites. PMID: 23185275
- High levels of nuclear phosphorylated CRMP-2 is associated with lung cancer. PMID: 23023514
- CRMP2 hyperphosphorylation is speci fi c to Alzheimer's disease and is not a common event in all forms of dementia and neurodegeneration, especially other tauopathies. PMID: 21860090
- findings suggest a major role of phosphorylated CRMP-2 as a mechanism involved in process retraction induced by reactive oxygen species PMID: 22443207
- HTLV-1 has the capacity to influence the CRMP2/PI3K/Akt axis thus to positively control cytoskeleton organization and lymphocyte migration. PMID: 22227566
- CRMP2 controls dendritic projection; the phosphorylation of CRMP2 at Ser522 is essential for proper dendritic field organization for axonal guidance and spine development . PMID: 22279220
- This review discusses the essential biology of CRMP2 in the context of nascent data implicating CRMP2 perturbations as either a correlate of, or plausible contributor to, diverse neuropathologies. PMID: 21271304
- Data support DPYSL2 and the surrounding genomic region as a susceptibility locus for schizophrenia. PMID: 21302347
- Data provide the first trafficking regulatory role for Crmp2 in non-neuronal cells and support a model in which Crmp2 is an important endocytic regulatory protein that links MICAL-L1.EHD1-based vesicular transport to dynein motors. PMID: 20801876
- DPYSL2 does not have a major function in schizophrenia in Japanese subjects. PMID: 20414250
- CRMP2 as a tubulin direct binder may be a GTPase-activating protein (GAP) of tubulin in neurite formation and its GAP activity may be regulated by an intramolecular interaction with an N-terminal inhibitory region. PMID: 19666111
- Aberrant expression of dihydropyrimidinase related proteins-2,-3 and -4 in fetal Down syndrome brain. PMID: 11771764
- No significant associations were found between five polymorphisms of the DRP-2 gene and Bipolar Disorder, nor were associations detected between either of the polymorphisms and bipolar subtypes I and II. PMID: 12951196
- Here we show that glial cell line-derived neurotrophic factor (GDNF) enhances CRMP-2 expression in TGW human neuroblastoma cells via activation of RET receptor tyrosine kinase. PMID: 15207709
- significant decrease of crmp-2 protein may represent or underlie impaired neuronal plasticity, neurodegeneration, wiring of the brain in mesial temporal lobe epilepsy PMID: 15672539
- CRMP-2 transports the Sra-1/WAVE1 complex to axons in a kinesin-1-dependent manner and thereby regulates axon outgrowth and formation PMID: 16260607
- collapsin response mediator protein-2 transcriptional activity is inhibited by all-trans-retinoic acid during SH-SY5Y neuroblastoma cell differentiation PMID: 17229153
- These observations implicate hyperphosphorylation of CRMP2 as an early event in the development of AD and suggest that it can be induced by a severe APP over-expression and/or processing defect. PMID: 17683481
- results indicate that that CRMP-2 may be a novel colorectal cancer biomarker PMID: 18203259
- association of neurofibromin and CRMP-2 is essential for neuronal cell differentiation PMID: 18218617
- relative resistance to phosphatases might be a common feature of Cdk5 substrates and could contribute to the hyperphosphorylation of CRMP2 and Tau observed in Alzheimer disease PMID: 18460467
- Data suggest that collapsin response mediator protein-2 (CRMP-2) is a novel calmodulin-binding protein and that CaM binding may play an important role in regulating CRMP-2 functions. PMID: 19151921
- Given that CRMP-2 is a key regulator of axon elongation, this interference with cytoplasmic dynein function by CRMP-2 might have an important role in axon formation, and neuronal development PMID: 19659462
- A significant association was found between a single nucleotide polymorphism of the DRP-2 gene and schizophrenia in a North American sample. PMID: 15858820
顯示更多
收起更多
-
亞細胞定位:Cytoplasm, cytosol. Cytoplasm, cytoskeleton. Membrane. Note=Tightly but non-covalently associated with membranes.
-
蛋白家族:Metallo-dependent hydrolases superfamily, Hydantoinase/dihydropyrimidinase family
-
組織特異性:Ubiquitous.
-
數據庫鏈接:
Most popular with customers
-
-
YWHAB Recombinant Monoclonal Antibody
Applications: ELISA, WB, IHC, IF, FC
Species Reactivity: Human, Mouse, Rat
-
Phospho-YAP1 (S127) Recombinant Monoclonal Antibody
Applications: ELISA, WB, IHC
Species Reactivity: Human
-
-
-
-
-